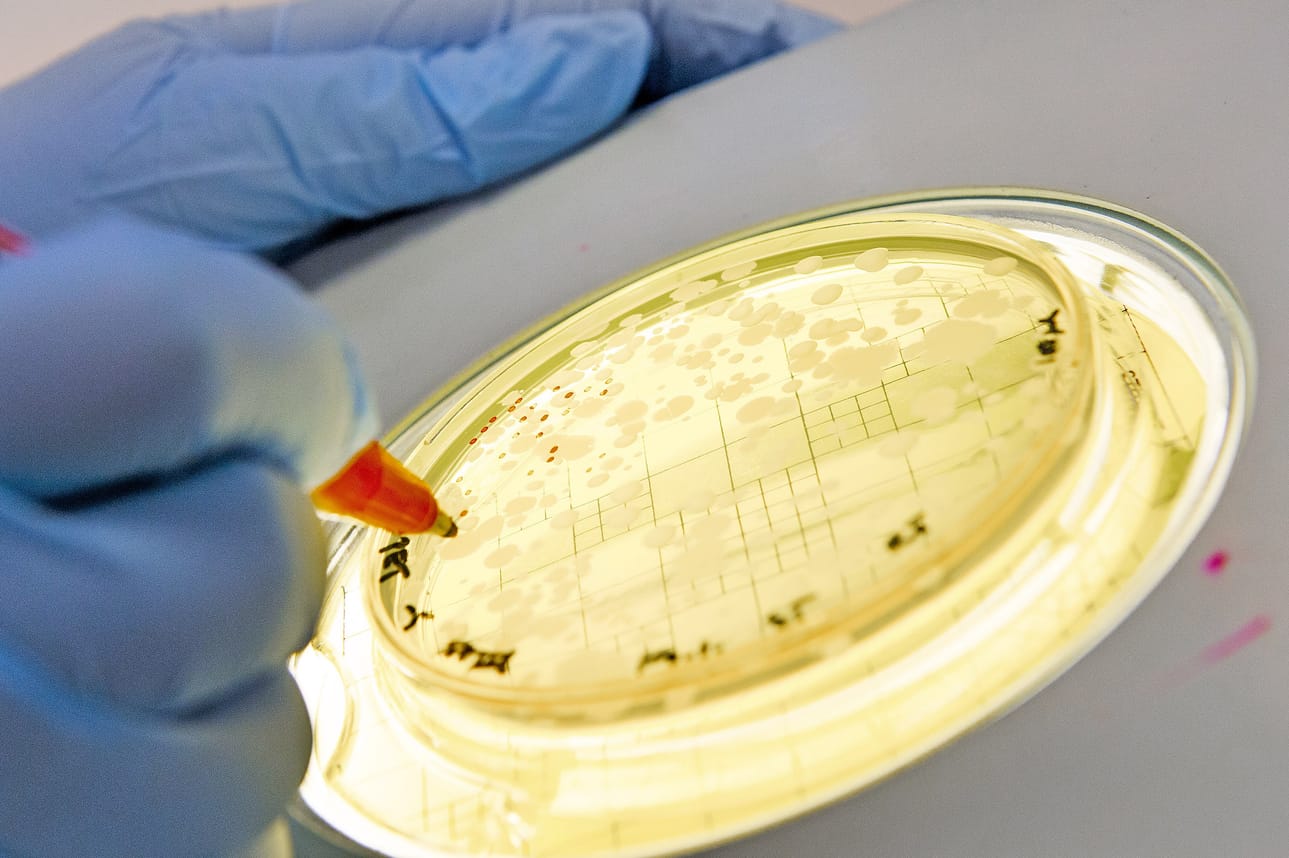
Turun yliopiston funktionaalisten elintarvikkeiden kehittämiskeskus testasi Lännen Median pyynnöstä, mitä probiootteja tuotteet oikeasti sisältävät.

Lännen Media selvitti Turun yliopistossa, mitä probioottisiksi väitetyt siivoustuotteet sisältävät. Lue, kannattaako niitä ostaa.
Turun yliopiston funktionaalisten elintarvikkeiden kehittämiskeskus testasi Lännen Median pyynnöstä Homcaren Bioswipe probioottisiksi väitetyt huone- ja eläinsuihkeen sekä pyykinpesuaineen.
Tuotteita myydään sekä suoramyynnissä että netissä.
WHO:n määritelmän mukaan probiootti tarkoittaa elävää mikrobivalmistetta, joka sopivana annoksena antaa isännälleen tutkitun ja todennetun terveydellisen hyödyn. Tavallisimmat probiootit ovat maitohappobakteereja ja bifidobakteereja.
Harhaanjohtavaa tietoa
Jo ennen testausta professori Seppo Salminen ihmettelee, miksei tuotteiden valmistusaineluettelossa kerrota, mitä probiootteja tuotteet sisältävät.
Huone- ja eläinsuihkeen tuotetiedoissa kyllä kerrotaan, että aine sisältää mikrobeja ja vettä, mutta ei sitä, kuinka paljon ja mitä mikrobeja.
– Tieto on puutteellista. Kuluttaja ei voi mitenkään tietää, mitä hän huoneilmaansa suihkii.
Kuten WHO:n määritelmä sanoo probiooteista, Seppo Salmisen mielestä kuluttajalle tulisi ilmoittaa tuotteesta saatava hyöty selkeästi.
– Jos kyse olisi elintarvikkeista, näin ympäripyöreät ainesosaluettelot eivät tulisi kysymykseenkään.
Tuotteiden mukana tulee vihkonen, jossa annetaan ymmärtää, että tuotteet sisältävät hyödyllisiä bakteereja, jotka syövät pinnoilta patogeenejä eli haitallisia bakteereita. Mainostekstissä myös kerrotaan probioottien syövän likaa ja rasvaa.
– En tiedä yhtäkään probioottia, joka söisi rasvaa, Salminen sanoo.
Kuluttajan annetaan mainoksista myös ymmärtää, että tuotteiden takana olisi tutkimusta. Lähdettä ei kuitenkaan kerrota.

Probiootteihin perehtynyt Salminen ei ole löytänyt yhtäkään tieteellistä artikkelia, joka käsittelisi probiootteja pesuaineissa. Sen sijaan huonespraysta löytyy yksi tutkimus.
– Soitin myös yhdysvaltaltalaisille ja brittiläisille kollegoilleni. Hekään eivät olleet kuulleet näistä tai mistään muistakaan probiootteja sisältävistä pesuaineista tai huonesuihkeista.
Pyykinpesuaineesta ei löydy mitään
Mainos väittää, että nestemäinen pyykinpesuaine sisältää probiootteja. Valmistusaineluettelossa Bacillus Ferment on ainoa ainesosa, joka viittaa probiootteihin. Purkin kyljessä myös kerrotaan, että pesuaineella voi pestä pyykkiä jopa 60 asteessa.
– Tuote ei täytä lupausta, jonka se mainostekstissä ja etiketissään antaa. Probiootti on aina elävä mikrobi, ja valtaosa mikrobeista kuolee 60 asteessa, kertoo professori Seppo Salminen.
Tuotetta testattiin Turun laboratoriossa kolme viikkoa. Siitä otettiin useita näytteitä. Yhdessäkään ei kasvanut mitään probioottia.
Suihkeista paljastuu ruuanpilaajabakteereita
Turun yliopiston laboratoriossa tutkittiin lisäksi kahta eri huonesuihketta, joita viljeltiin kolme eri kertaa. Ensimmäisellä kerralla tutkija luuli, että tuloksissa on jotakin vikaa, kun mikrobit kasvoivat niin nopeasti ja runsaasti huone- ja eläinsuihkeessa.
Näidenkään tuotteiden ainesosaluettelossa ei kuitenkaan kerrota, kuinka paljon mikrobeja ne sisältävät.
– Aina pitäisi pystyä osoittamaan annos, joka olisi terveydelle hyödyllinen. Tätä ei ole kerrottu.
Eläimille on testattu muun muassa suun kautta annettavia probiootteja. Ne toimivat, jos probiootit on eristetty saman lajin eläimestä. Esimerkiksi hevosen probiootit eivät toimi koiralla.
Pet spray ja Room spray -tuotteista löytyi useita Bacillus-kantoja, muun muassa Bacillus subtilis. Nämä eivät ole maitohappobakteereita, vaan itiöllisiä bakteereita, joita käytetään esimerkiksi Aasiassa eläinprobiootteina. Niitä esiintyy myös ruuan pilaajabakteereina.
– Ei tunnu hyvältä ajatukselta suihkuttaa koiraan bacilluksia, Salminen pohtii.
Salmisen laboratoriossa jatketaan tutkimuksia muun muassa pesuaineen osalta. Salminen haluaa vielä selvittää, mitä pesun aikana tapahtuu.

Maahantuoja ymmällään
Homcaren tuotelinja- ja logistiikkajohtaja Tuija Nemlander kertoo, että testatut kolme tuotetta sisältävät Bacillus-kantaan kuuluvia bakteereja.
– Tarkempia bakteerin nimiä ei lue tuoteselosteissa, koska tuotteiden valmistaja haluaa pitää kiinni tuotesalaisuuksistaan. Kemikaalilainsäädäntö ei velvoita tarkkojen tuotesisältöjen painamista esimerkiksi tuotepakkaukseen.
Tutkimustemme mukaan pyykinpesuaine ei kuitenkaan sisällä mitään elävää probioottia, vaikka mainos niin lupaa?
– Kyllä sen pitäisi sisältää. Pyydämme valmistajaa selvittämään, miksi tutkimuksessanne ei niitä löytynyt.
Probioottiset pesuaineet
Netissä ja suoramyynnissä kuluttajille kaupataan ekologisia ja probiootteja sisältäviä pesuaineita.
Lännen Media selvitti, sisältävätkö tuotteet oikeasti probiootteja.
Kolme tuotetta, joissa valmistaja väittää olevan probiootteja, lähetettiin Turun yliopiston funktionaalisten elintarvikkeiden kehittämiskeskukseen. Siellä tuotteet testattiin laboratoriossa professori Seppo Salmisen johdolla.
Nestemäisestä pyykinpesuaineesta ei löytynyt mitään. Sen sijaan huone- ja eläinspraystä löytyi Bacillus subtilis -bakteereja, jotka eivät ole maitohappobakteereita, vaan itiöllisiä bakteereja.
WHO:n määritelmän mukaan probiootti tarkoittaa elävää mikrobivalmistetta, joka sopivana annoksena antaa isännälleen tutkitun ja todennetun terveydellisen hyödyn.